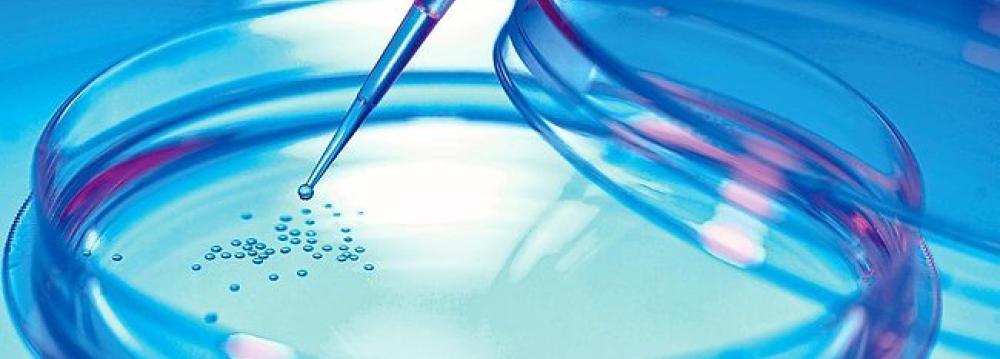

About 100 cases of stem cell transplants in the country each year are received from matching but unrelated donors, said head of the Iran Blood Transfusion Organization. “Around 8,000 patients are in need of transplantation and could receive stem cells from unrelated donors,” said Ali Akbar Pourfathollah, IRNA reported. Only 30% of patients needing stem cell transplants have an available match in their family and 70% have to find a donor through a search in the network of donor registries. “Approximately, 95% of patients will find at least one acceptable match,” from an unrelated donor, he said. Noting that about 50% of all transplants in the world involve unrelated donors, he said a competent networking system among medical facilities and donation centers could help reach out to almost all patients in need of stem cell transplants in the country.